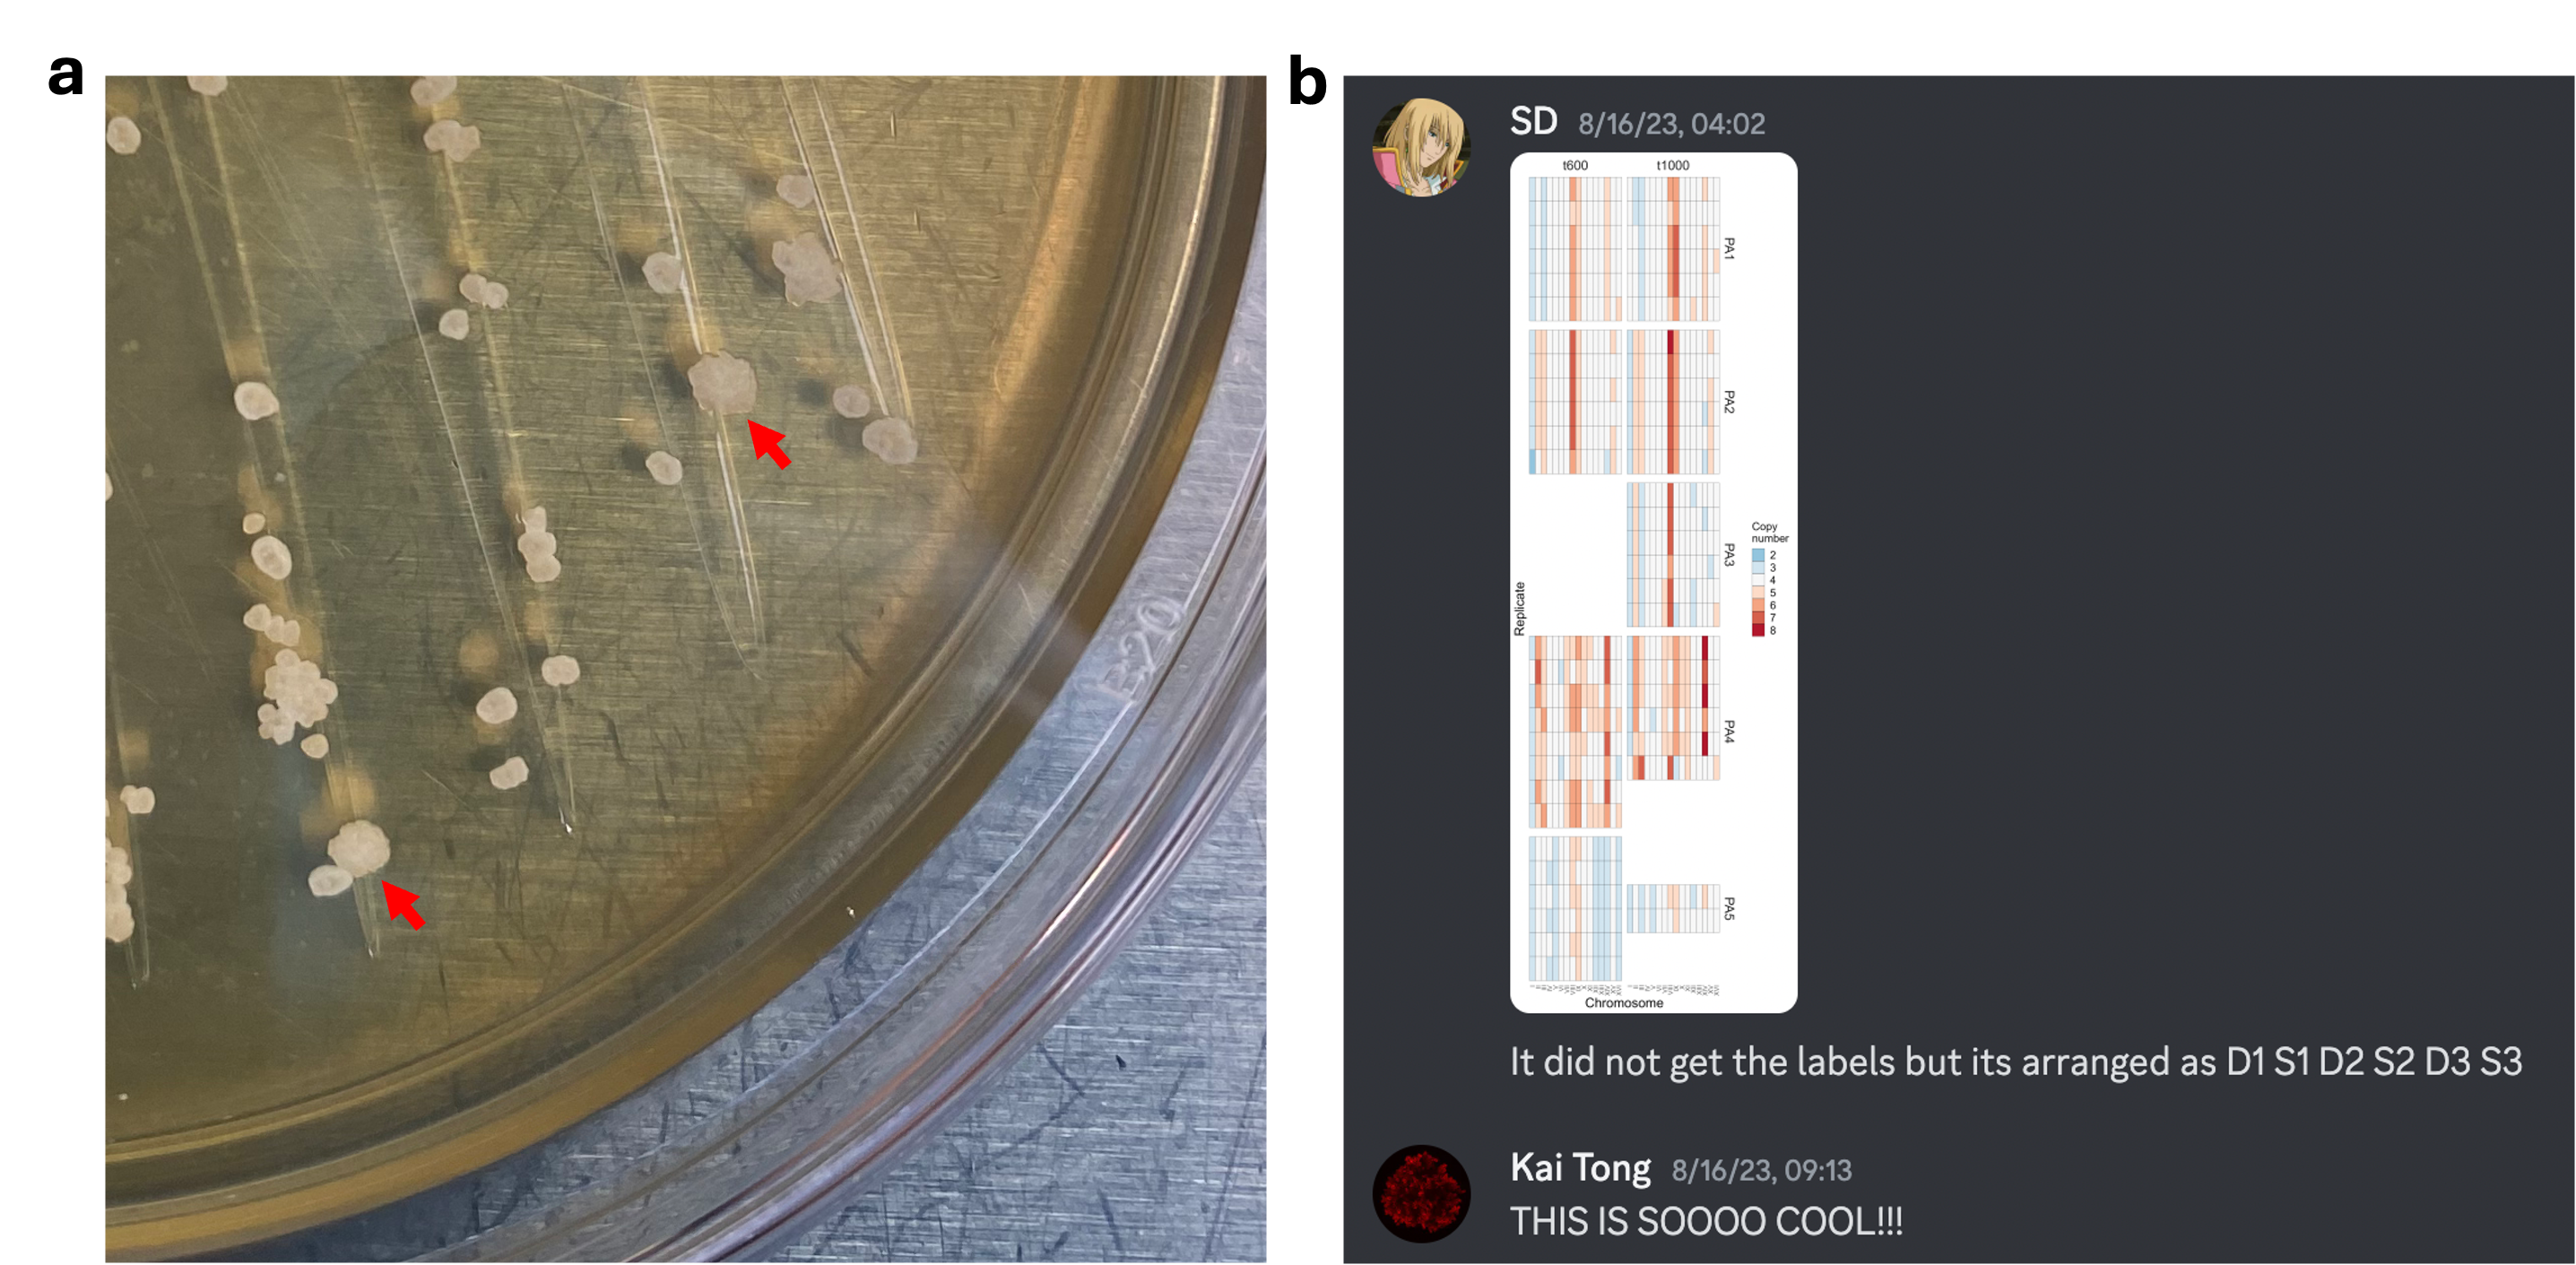

A long-term evolution experiment for whole-genome duplication
Published in Ecology & Evolution, Protocols & Methods, and Genetics & Genomics
Scientific progress is rarely linear. Instead, it unfolds through many interconnected paths, often converging in unexpected ways. It's at these intersections where truly exciting discoveries occur. This is my personal account of the stories behind our recent paper, highlighting the key moments and the people who made it all possible.
Before the beginning
In an undergraduate class in 2016, my classmate, Yezi Xiang, shared her research on how whole-genome duplication (WGD) shaped plant evolution. This was my first encounter of WGD, and I got immediately captivated by the grand evolutionary narrative of how such dramatic genomic shift impacted organismal adaptations and radiations. For my PhD, I joined William Ratcliff’s lab at Georgia Tech in 2018, who studies experimental evolution of multicellularity using snowflake yeast (multicellular Saccharomyces cerevisiae). Inspired by Anna Selmecki et al’s work in 2015 showing that polyploidy can drive faster adaptation in unicellular yeast1, I wondered how that may unfold in a multicellular system, potentially leading to novel phenotypes on the multicellular scale.
This idea intrigued Vivian Cheng and Daniella Haas (Fig. 1a), two freshman undergraduate students I was mentoring, and they took it on as their independent project in summer 2019. The first step was to genetically engineer tetraploid snowflake yeast, a technically challenging endeavor made more difficult by COVID-19 – the lab was shut down for several months, and due to visa issues, I was locked out of the US for almost two years and had to mentor them remotely. It was not until spring 2022 (the year in which all three of us were supposed to graduate) that we were close to the end of the tunnel. Vivian decided to stay for another month after graduation to complete the tetraploid construction, and her dedication paid off (Fig. 1b). Under the microscope, the tetraploid snowflake yeast is visibly larger than its diploid counterpart, consisting of larger, longer cells (Fig. 1c). On Vivian’s last day in the lab, before she left for a PhD program at UIUC, we both realized that it was the end of a four-year era: her first lab experience, and my first mentoring experience. However, neither of us realized at that time how crucial their work would become.

Fig. 1 | Vivian and Daniella genetically engineered tetraploid snowflake yeast. a, Vivian (left) and Daniella (right) presented their work in an undergraduate research symposium in spring 2022. b, Vivian (left foot) completed the genetic construction of tetraploid snowflake yeast after staying in the lab for another month after graduation. c, The first images of tetraploid, diploid, and haploid snowflake yeast and unicellular yeast (photo of lab computer taken on June 2, 2022).
Eureka moment
In summer 2022, four of us from the Ratcliff Lab – Will Ratcliff, Ozan Bozdag, Tony Burnetti, and me – went to teach at the Physiology Course at the Marine Biological Laboratory in Woods Hole. Over several sleepless weeks, we brainstormed new ideas, fought for microscopes, enjoyed popovers (and lab squid barbecues), and made a lot of fun with new friends. We brought some strains for students to work on, most coming from our Multicellularity Long Term Evolution Experiment (MuLTEE)2.
Inspired by Richard Lenski’s LTEE in E. coli (which has been continuously run since 1988)3, the MuLTEE was pioneered by Ozan to explore the open-ended evolution of nascent multicellular organisms. Ozan subjected mixotrophic, anaerobic, and aerobic populations (PM, PA, and PO, respectively) of diploid snowflake yeast to daily selection for larger size and had already run them for over 1000 days (~5000 generations) by that time. All populations evolved larger clusters, and most strikingly, we observed the de novo origin of macroscopic multicellularity in all PAs within 600 days2.
When students became more independent, we had a bit of free time to work on our own projects. When I was staring at one piece of my recently-generated data, I started to have a hunch that some evolved strains in the MuLTEE might be genomically unstable. Then one day, Ozan showed me a surprising result: most evolved mutations in PM/PA t1000 isolates had allele frequencies of ~25% (Fig. 2a), which seemed odd for supposedly diploid organisms (as one would expect a frequency of 50% for heterozygotes and 100% for homozygotes, but not 25%). This, Ozan suggested, would make sense if they had become tetraploids. I doubted this possibility, however, as tetraploid yeast is notoriously unstable and rapidly reverted to diploidy within a few hundred generations in multiple evolution experiments. A simple way to explain Ozan’s results could just be errors in genome sequencing or analysis. Indeed, people tend to ignore or deny facts that they do not understand, so did I, though luckily only for a few days.
On July 14, 2022, perhaps due to that intense and intellectually-stimulating environment in Woods Hole, a eureka moment hit me. It is tempting to describe that moment in a linear, logical way, but that was not what happened. It was more like many unrelated dots suddenly connecting together: engineered tetraploid snowflake yeast is larger, evolved snowflake yeast is larger under selection for larger size and may be unstable, allele frequency pointing to tetraploidy, and tetraploid yeast known to be unstable… Separate lines of evidence started to be pieced together by logic, but it took me a while to organize my thoughts: if tetraploidy indeed arises and persists for thousands of generations in the MuLTEE, that may be because the selection for larger size in our experiment drives the evolution of tetraploidy (because tetraploid clusters consist of larger, longer cells and thus are larger than diploids) and continuously applying the same selection also maintains tetraploidy despite its intrinsic genomic instability (Fig. 2b). In other words, it may be this sustained selection on the immediate phenotypic effects of polyploidy that distinguished our system from previous evolution experiments. Here, instead of being costly and transient, polyploidy itself may be beneficial, and thus arise and become persistent.
I posted this on our lab Discord, and Will immediately understood my idea, proposed experiments to test it, and suggested that this could lead to a short paper (though on this last matter, he was wrong: this turned out to be the most data-rich paper our lab has ever produced; Fig. 2b). I got super excited and spent all my spare time in the last few days in Woods Hole reading about yeast polyploidy. However, I was reluctant to carry out this project - my thesis defense was only four months away and I would be busy soon, plus I was uncertain, even if all experiments went smoothly and my hypothesis turned to be true, whether it only applies to our special system or holds more general implications. On my last day in Woods Hole, I was walking past the Eel Pond, where the marine creatures inspired me about the wonder of multicellular life every day, and I made up my mind to put this project into action. Honestly, I was driven more by my gut feeling – WGD is important and MuLTEE is unique, so their combination would be so cool. Plus, deep down, I wanted to test these cool ideas myself.

Fig. 2 | Eureka moment in Woods Hole. a, Ozan shared his mutation allele frequency data of PM/PA t1000 isolates, and he proposed that they might be tetraploids (screenshot taken on a quick analysis in Excel). b, In Discord, I posted my hypothesis about WGD evolution in the MuLTEE (though I was wrong in the aspect that tetraploidy itself contributes directly to macroscopic size), and Will quickly replied with thoughts and proposed experiments.
Two intense months
This was followed by two intense months, over which I developed several new protocols (including an imaging-based method for measuring ploidy of multicellular yeast) and conducted a series of experiments that together confirmed the above hypothesis. It turned out that tetraploidy convergently evolved in all ten PM and PA populations, arising very early in the MuLTEE, and has been maintained for ~5,000 generations (and counting). This essentially makes the MuLTEE not only the longest-running multicellularity evolution experiment, but also the longest-running polyploidy evolution experiment. This also made Vivian and Daniella’s legacy strains the cornerstone of the whole project, not only for examining the immediate phenotypic effects and adaptive benefits of tetraploidy, but also for serving as the control strains for estimating the ploidy of any strain of interest. Now these strains are continuing to be used by everyone in the lab, and ploidy measurement has become another key characterization for any newly isolated strain from the MuLTEE.
In retrospect, we set out to engineer polyploidy for experimental evolution, but interestingly, we found in the end that the genomes in the MuLTEE had already quietly doubled, which almost went unnoticed even though we had been staring at these strains for years. This finding also allowed me to solve a mystery buried even deeper in our lab’s history. More than a decade ago, in Will’s initial evolution experiment where he evolved unicellular yeast into multicellular clusters and coined them “snowflake yeast”4, he also noticed cell size doubling not long after snowflake yeast evolved5,6. However, over years we struggled to identify the point mutations underpinning this key phenotypic change, and now we realize (and experimentally confirmed) that, just like in the MuLTEE, it was rooted in something much more dramatic and fundamental.
Moreover, I am truly grateful for the generosity of Peter Conlin, a postdoc in our lab, as well as Saranya Gourisetti and Harley Yopp, two undergraduate students that Peter was mentoring (Fig. 3). In 2021, they performed an evolution experiment aiming to examine the loss of multicellularity in PM/PA t1000 strains, by selecting against larger size for ~500 generations. While they didn't achieve their original goal of reverting to single cells (though the clusters did become smaller), Peter generously offered that their experiment could be co-opted to test how tetraploidy was maintained in the MuLTEE. When we examined their evolved populations, we found convergent ploidy reduction – what we would predict if tetraploidy was maintained by selection for larger size while retaining intrinsic genomic instability. This intrinsic instability of evolved tetraploids was further supported by a two-month mutation accumulation experiment (thanks to the suggestion of our reviewers), where we also observed ploidy reduction when selection was minimized.

Fig. 3 | Harley (left) and Saranya (right) presented their work on the counter-selection experiment in an undergraduate research symposium in spring 2023.
Final piece
Following my thesis defense, our manuscript was largely in shape, but I decided to stay in the lab for a few more months to tie up a few loose ends. Notably among these, I reached out to Tom Day, our in-lab biophysicist, who helped disentangle the effects of larger and longer cells on larger clusters using biophysical modeling. However, there is a missing piece in the puzzle that continued to bother me. It is well-known that polyploid genomes are unstable and tend to become aneuploid, which can offer novel genetic routes for adaptation. Not surprisingly, I found cases of aneuploidy in the evolved tetraploids in the MuLTEE. However, while all PMs are euploid or near-euploid, all PAs display extensive aneuploidy. Why? It did not escape my notice that this distinction is correlated with the divergent multicellular evolution under the two conditions: while PMs stayed microscopic over 1000 days of evolution, PAs evolved macroscopic size. It would be an exciting discovery if aneuploidy somehow contributed to the origin of macroscopic multicellularity in the MuLTEE, and the patterns of karyotype evolution in PAs indeed strongly pointed to this.
But how to test this directly? While approaching this question in other ways (though all failed eventually), I discussed a “simple” idea with Sayantan Datta, a first-year PhD student I was mentoring. This idea was based on an anecdotal discovery that I had several months earlier: when I streaked out macroscopic PA t600/t1000 isolates on an agar plate, most colonies were donut-shaped, but there are few colonies that were larger, more spread-out (Fig. 4a). I was curious about what this difference means, so despite tons of other things going on, I managed to find some time to figure this out. The answer is simple: spread colonies can no longer form macroscopic clusters, likely due to certain genetic changes. Several months later, this curiosity-driven discovery offered a great strategy to screen for spontaneous losses of macroscopic size, and through genome sequencing we can examine if karyotype changes are involved in this process.
Sayantan was excited to try this out, and it eventually took him half a year of hard work to screen hundreds of plates to isolate and characterize 25 donut-spread pairs from nine macroscopic strains. Our technician, Dung Lac, also offered tremendous support in extracting their genomes for sequencing. The night of August 15, 2023 was unforgettable, when Sayantan and I worked together over Discord until 3am to analyze the first (and major) batch of sequencing data (in fact, I was not aware until the following morning that Sayantan stayed up a bit later to organize the plots). Beyond our wildest expectation, all but one donut-to-spread transitions involved karyotype changes (Fig. 4b). Later, I conducted more systematic bioinformatic analyses to demonstrate that aneuploidy underpins not only the loss of macroscopic size in donut-to-spread transitions, but also its evolutionary origin in the MuLTEE. This extends the impacts of WGD in the MuLTEE: WGD not only confers immediate selective advantages, but also fuels longer-term innovations through aneuploidy.
Fig. 4 | Spontaneous donut-to-spread transitions revealed the role of aneuploidy in the origin of macroscopic multicellularity. a, I anecdotally found that macroscopic snowflake yeast can sometimes form larger, more spread-out colonies (indicated by red arrows) among normal, donut-shaped colonies (this first photo showing spread colonies was taken on Sept. 9, 2022). b, Sayantan stayed up till 4am to plot the karyotype data, revealing widespread karyotype changes during donut-to-spread transitions.
Bigger picture
In August 2023, I moved to Boston University for postdoc when Sayantan was doing the last few rounds of screening. I am truly grateful for my postdoc advisor, Ahmad (Mo) Khalil, for his understanding, support, and thoughtful suggestions when I spent a decent amount of time in the lab wrapping up this WGD paper. When winter arrives, I like to wander around on the snowy Boston streets. The white brings peace to the mind, and the noise keeps the nerves firing, when I started pondering more deeply and broadly about our work.
WGD, like multicellularity, evolved many times in history and is a powerful driver of organismal evolution, but an experimental system for directly studying the de novo evolution of WGD is lacking. When we started the MuLTEE, we had no intention of studying WGD. Yet here we find ourselves running not just the longest-running multicellularity evolution experiment, but also the longest-running polyploidy evolution experiment. For the first time, we observed in the lab how WGD arises, persists, and drives both short-term and long-term adaptations. WGD is known to produce immediate phenotypic effects (many of which are rooted in increased cell size), but the costs and instability of nascent WGD raise questions of how it could initially rise and be maintained. With our serendipitous discovery, we experimentally demonstrated that sustained selection on the immediate phenotypic effects of WGD is sufficient to drive both its origin and long-term maintenance, despite the intrinsic instability of polyploid genomes. Further, WGD doesn’t just confer short-term adaptive benefits. Once established, it can open new dimensions of genetic variation (e.g., via aneuploidy) that can underpin long-term evolutionary innovations. These insights also reveal an interesting parallel in our system: polyploidy, just like multicellularity, can be costly, and is only expected to evolve under certain selective conditions; once established, however, it can catalyze long-term evolutionary changes.
The MuLTEE is now approaching 2,000 days or 10,000 generations (thanks to Ozan’s incredible work ethic), and we plan to run it for decades. One of the most exciting things about long-term experimental evolution is that it is a hypothesis-generating machine, taking us into novel territory we did not even know was on the map when we initially set out. We did not set out to study WGD, just like we did not set out to study entanglement2, heat shock proteins7, coexistence8, or hydrodynamic flows9. As the MuLTEE proceeds, we expect that it will continue to serve as a testbed for a range of hypotheses, about WGD, multicellularity, cell biology, ecology, biophysics, and more.
Overall, our experimental system (and our reviewers) was kind to us, allowing us to gain clean, important insights without a frustrating number of obstacles. However, the real joy was the outstanding collaboration that made up this incredible team: Vivian and Daniella’s strain constructions, Ozan’s bioinformatic detective work, Peter, Saranya, and Harley’s willingness to recontextualize their work, Sayantan’s relentless work ethic, Tom and Dung’s essential help with biophysical modeling and molecular biology, respectively, and the leadership of Will and Mo. As Will nicely put it when our paper was accepted, “What I really love is how it is also not a story of individual accomplishment, but actually incredible teamwork and mentorship”.
References
1 Selmecki, A. M. et al. Polyploidy can drive rapid adaptation in yeast. Nature 519, 349-352, doi:10.1038/nature14187 (2015).
2 Bozdag, G. O. et al. De novo evolution of macroscopic multicellularity. Nature 617, 747-754, doi:10.1038/s41586-023-06052-1 (2023).
3 Good, B. H., McDonald, M. J., Barrick, J. E., Lenski, R. E. & Desai, M. M. The dynamics of molecular evolution over 60,000 generations. Nature 551, 45-50, doi:10.1038/nature24287 (2017).
4 Ratcliff, W. C., Denison, R. F., Borrello, M. & Travisano, M. Experimental evolution of multicellularity. Proc Natl Acad Sci U S A 109, 1595-1600, doi:10.1073/pnas.1115323109 (2012).
5 Ratcliff, W. C., Pentz, J. T. & Travisano, M. Tempo and mode of multicellular adaptation in experimentally evolved Saccharomyces cerevisiae. Evolution 67, 1573-1581, doi:10.1111/evo.12101 (2013).
6 Ratcliff, W. C., Fankhauser, J. D., Rogers, D. W., Greig, D. & Travisano, M. Origins of multicellular evolvability in snowflake yeast. Nat Commun 6, 6102, doi:10.1038/ncomms7102 (2015).
7 Montrose, K., Lac, D. T., Burnetti, A. J., Tong, K., Bozdag, G. O., Hukkanen, M., Ratcliff, W. C., Saarikangas, J. Proteostatic tuning underpins the evolution of novel multicellular traits. Science Advances 10, eadn2706, doi:10.1126/sciadv.adn270 (2024).
8 Pineau, R. M. et al. Emergence and maintenance of stable coexistence during a long-term multicellular evolution experiment. Nat Ecol Evol 8, 1010-1020, doi:10.1038/s41559-024-02367-y (2024).
9 Narayanasamy, N. et al. Metabolically-driven flows enable exponential growth in macroscopic multicellular yeast. bioRxiv, doi:10.1101/2024.06.19.599734 (2024).
Follow the Topic
-
Nature
A weekly international journal publishing the finest peer-reviewed research in all fields of science and technology on the basis of its originality, importance, interdisciplinary interest, timeliness, accessibility, elegance and surprising conclusions.
Please sign in or register for FREE
If you are a registered user on Research Communities by Springer Nature, please sign in